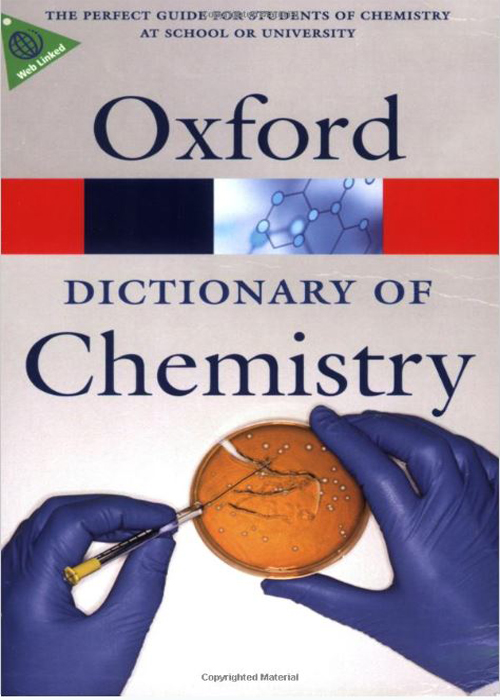

Oxford Dictionary of Chemistry Quick Reference by John Daintith
Rs.1,050.00
- Series: Oxford Quick Reference
- Paperback: 584 pages
- Publisher: Oxford University Press; 6 edition (April 15, 2008)
- Language: English
- ISBN : 9788172454913
- Product Dimensions: 7.7 x 1.4 x 5 inches
Additional Information
Product Description
Fully revised and updated, the Sixth Edition of this popular dictionary is the ideal reference resource for students of chemistry, either in high school or in college. The new edition features more than 4,300 entries, including hundreds of new terms. The Dictionary covers all aspects of chemistry--from physical chemistry to biochemistry--including topics such as metallurgy, materials science, forensic science, and geology. There are also biographical entries on key figures in the field.
The book has single or double-page feature articles on important topics such as polymers and crystal defects, and chronologies that chart the main discoveries in such fields as atomic theory, biochemistry, explosives, and plastics. The new edition also features web links accessed via a companion website, featuring additional information that is regularly updated to ensure that it stays fresh. The volume concludes with nine appendices, including the periodic table, SI units, the chemical elements, Nobel prizewinners, and useful websites.
Have one to sell? Click Here